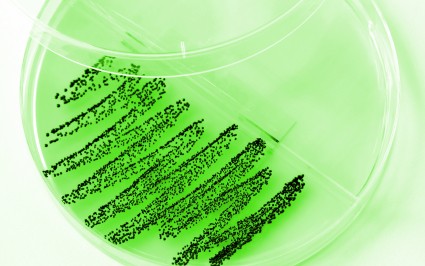

Staphylococci are one of the most common inhabitants of the skin and mucous membranes of humans. Generally, they are non-pathogenic, causing no significant problems. However, they will become pathogenic when they are able to invade into the body and contribute to superficial deep infections, as well systemic toxicity. They are particularly troublesome as a source of surgical wounds, peri-prosthetic and systemic infections. In the hospital setting, they are the most common source of nosocomial infections. They may be incriminated in many cases of food poisoning.
Staphylococcus Aureus is the most significant organism in this genus that afflicts humans. This group is divided into those that can cause plasma to clot (coagulase positive) and those, less virulent, which are unable to cause clotting (coagulase negative). These organisms enjoy a non-pathogenic colonization, living and being carried in the nasopharynx, maxillae, vagina, skin and perineum. During menstruation, their numbers double in the vagina.
This bacterium is found in 20-30% of the anterior nares of normal healthy people. Conversely, in the hospital setting, where the personnel are exposed frequently and repeatedly to staphylococcal, a colonization approaching 60% is demonstrated. Frequent health care visitors, such as dialysis patients, are ready recipients of staphylococcal colonization. Individuals with compromised immune systems, and chronic skin conditions, as well as type I Diabetics are especially susceptible to colonization. It is estimated that 5-6% of all new hospital admissions will develop Hospital acquired infections, of which Staphylococci are the most common.
Once an individual is colonized, the organism can persist for long periods and has a half-life of 40 months. Those organism acquired in the health setting are very likely to be resistant to the more commonly used antibiotics, especially Oxacillin and Methicillin and are referred to as MRSA (Methicillin Resistant Staphylococcal Aureus). Up to 50% of Staphylococcal strains seen in the hospital are resistant to Methicillin. Outside of the health arena, MRSA is rarely a danger to the general public. But in the health setting, this organism is responsible for 25% of hospital bloodstream infections. Debilitated, burned, post-operative surgical and orthopedic wound patients are especially vulnerable to this bacterium. “It is estimated that the odds of dying from an MRSA infection in the hospital are almost twofold higher than if the infection were not caused by a resistant infection“.
Since the introduction of antibiotics, bacteria and virus have begun to develop mechanism whereby resistance to these antibiotics are achieved, resulting in the emergence of very virulent organisms such as MRSA and VRE. Particularly in the hospital setting, where antibiotics are used so often, this transformation from common antibiotic sensitive organisms to resistant organism has been observed with alarming frequency. This has begun to manifest itself even in the long term setting such as nursing homes and rehabitative centers. Even in the community setting with the frequent and increasing use of antibiotics to treat Sinusitis and childhood ear infections, antibiotic resistant organisms have begun to flourish. Patients failing to take the full course of treatment, stopping the medication before they are all taken, because they feel better, has allowed the surviving bacteria, even though reduced in number, to develop antibiotic resistance.
In recent years, studies have demonstrated that MRSA is often picked up in the hospital and carried home by both the patient and the visitors. Screening patients, who are transferred from other hospitals has begun to gain a foothold in an effort to stem this spread.
Pathogenesis
Colonization, either from the individual or other human contacts and surfaces, affords the staphylococcus access to disrupted epithelial or mucosal barriers, where it may become pathogenic. Once it gains access to the inner tissues, it is able to set up infection, inflammation and fever. This invasion may manifest clinically as skin infections (ulcers and boils), pneumonia, sepsis, deep abscesses and even death. Spread of the organism is by direct physical contact, as well as contact with objects, such as sheets, towels, dressings, clothes, etc. that have been contaminated by either infected skin or Respiratory droplets. Airborne spread is felt to be possible in some situations.
Some of these organisms, especially Staphylococci, can manifest there pathological influence by the emission of toxins, which can be deadly to humans. The Toxic Shock Syndrome, from vaginal tampons, left in for extended periods, has been associated with Staphylococcal toxins, and is associated with many deaths.
Epidemics of MRSA have occurred in Intensive care units, Orthopedic units, premature nurseries, where neonates, with immature immune systems, reside. The economic and health impact of MRSA has become enormous. Now, certain groups are suggesting that women have their babies at home where resistant organisms are less likely to be found.
It has been postulated, from studies, that the longer one is required to stay in the hospital, or in the Intensive care unit, had numerous antibiotics, or antibiotics for a long period of time, or is exposed to medical devices, the more likely they will contact MRSA. Chronic Staphylococcal infections with recurrent infections has been proposed by some researchers, and is currently under investigation. Even Chronic Fatigue Syndrome has been linked as one possible result of chronic infection as a reaction to toxins emitted by the staphylococcal. Septic Arthritis has been associated with MRSA, among other organisms.
TREATMENT
Colonized patients, who are not scheduled for surgery, are not candidates for treatment. The pre-antibiotic era management of wounds is still an acceptable approach to superficial wounds and abscesses. Incision and drainage of the wound or sore can often heal the lesion without the use of antibiotics. Intravenous antibiotics are necessary for deep seated infections, and consist of potentially toxic drugs, which require hospitalization, intravenous administration and close vigilance.
Removal of prosthetic apparatuses may be necessary if the deep peri- prosthesis infection is discovered some time after the initial implantation. This may require re-implantation of a new prosthesis after the wound has healed.
PREVENTION
The use of antibiotics, either systemically or topically or both has been tried in order to decrease the colonization of MRSA in the hospital setting. Initially there were many failures in eradicating colonization in the nares and preventing recolonization. The relatively successful combinations have been rifampin with trimthoprim sulfamethoxazole, rifampin and minocycline, and mupirocin ointment alone.
Mupirocin ointment has received particular attention of late, since it is easy to apply and has few side effects. Typically, this agent is applied twice a day for 5 days. This has been fairly successful in patients who were to undergo surgery, where the risk of developing MRSA surgical site infection varies from 2 to 14 times higher than those with negative nares cultures. In studies, there was an approximate 50% decrease in the rate of infections in those who received the ointment. It decolorized the nares in 83% of those who received it for 5 days, and 90% in those, who received it for 6 days.
Recently, there have emerged rapid tests able to identify Staphylococcus Aureus within 15 min. to 2 hrs., which may allow to institution of this therapy to be implemented expeditiously, in those scheduled to undergo surgery or who are susceptible to infection, because of reduced resistance.
Even a recent DNA vaccine has been tried, and may offer a different and effective approach to MRSA.
Antibiotics, such as Vancomycin have been used to treat MRSA successfully, but resistance is rapidly developing and these are very virulent drugs, with serious potential side effects, and must be given intravenously in the hospital. New drugs are being sought for in an ever increasing frenzy.
Finally, simple universal rules of health, such as washing of hands by the health personnel between patients, for 20 seconds with an antibacterial soap, and using paper hand towels to flush toilets and open bathroom doors, after washing, will help in diminishing the prevelance of this organism in the hospital surroundings, where it is most dangerous. Insisting that your
Nurse and Physician wash his hands, as described, before touching you or room furniture or articles may deter transfer of resistant organisms. Wearing and changing gloves would be a better approach, but has yet to be accepted.
A Japanese study suggested the following steps to control MRSA: 1.) Constant and careful surveillance, 2.) regular risk factor analyses, 3.) the optimal administration of antibiotics, 4.) the education of all hospital staff. They strategically placed hand washing equipment, used disposable gloves and contaminated waste bags, and noted the hospital incidence if MRSA to be reduced considerably.
“Patients with MRSA should be physically isolated in a single room with the door remaining closed and the room regularly damp dusted, or they should be nursed in a special ward away from other non-infected patients. If a patient is readmitted to the original hospital or to another hospital, within some specified period of time and was know to have a previous MRSA infection, this patient should be physically separated or placed in isolation immediately to reduce the possibility of spread to others. After an MRSA patient is discharged from the hospital, their room should be comprehensively cleaned and all linen and other clinical waste disposed of in special bags.” (4)
VANCOMYCIN RESISTANT ENTEROCOCCUS
Enterococcus, like Staphyloccus, is a normal inhabitant of the body. It resides, generally, in a non-pathogenic manner in the intestinal and female genital tracts of humans. But, it too, can become a pathogen, once it gains access within the body, especially in an enviroment conducive to inflammation or where the immune system is impaired.
And like Staph, it too has, over the years, from exposure to antibiotics, developed resistance, which now expresses itself as a resistance to Vancomycin, leaving us almost defenseless before it’s onslaught. It too, was originally thought to be attributed to endogenous sources within the individual patient, as the origin of the bacteria’s presence. But, like MRSA, recent outbreaks have indicated that patient-to-patient transmission of the microorganism can occur, either through direct contact or even through indirect contact. This can occur via a) the hands of the personnel or b) contaminated environment or equipment.
Also, like Staph, certain patient groups are susceptible to it’s invasion. These include the immunologically compromised, critically ill or debilitated patients, persons who have had an intraabdominal or cardio-thoracic surgical procedure, as well as those with indwelling urinary or central venous catheters or those with implantations of prosthetic materials or devices. It too, is often found to be plentiful in Special care units such as ICU. Streptococci have also been associated with Toxic Shock Syndrome, because of their penchant to produce toxins.
And it has recently been discovered, that one genus of bacteria can share it’s antibiotic resistance to that of another. So an MRSA, which is not resistant to Vancomycin, can, in the presence of VRE, rapidly develop an equal resistance to Vancomycin.
PREVENTION AND TREATMENT
Prevention involves all the aforementioned Universal health precautions referable to MRSA. They include, judicious hand washing, use of gloves, isolation precautions, care and cleaning of equipment and the patient environment. In this particular case, intensified fecal screening for VRE might facilitate earlier identification of colonized patients, leading to more efficient containment of the microorganism. And equally, since colonization can remain for prolonged periods of time after discharge from the hospital, there should be a method of highlighting those patients with previous VRE infections, so that they can be immediately identified, when they return to the hospital environment.
Although, in contrast to MRSA, hospital personnel have rarely been associated with the transmission of this microorganism, the possibility still remains. So, hospital personnel should still be examined for chronic skin and nail problems and perform hand and rectal swab cultures for completeness sake.
As to prophylaxis for major surgical procedures, which involve implantation of prosthetic materials or devices, a single dose of vancomycin administered immediately before surgery is sufficient unless the procedure lasts greater than 6 hours, in which case the dose should be repeated. No more than 2 doses should be administered.
Since Vancomycin is the most common medication used for MRSA, the HICPAC ( Hospital Infection Control Practices Advisory Committee, has published guidelines concerning situations in which the use of Vancomycin should be discouraged. Their advice also includes recommendation for Screening procedures for detecting VRE in Hospitals where VER have not been detected and Detecting and Reporting MRSA and VRSE.
Treatment of VRE, presently consists of a combination of a penicillin and an aminoglycoside.
References:
1.) The significance of MRSA infection in genl sugery: a multivariate analysis of risk factors and preventive approaches: Surg Today. 1993;23(10):880-4/
2.) Risk factors for persistent carriage of MRSA: Clin Infec Dis. 2000 Dec;31(16): 1380-5. Epub 2000 Nov.
3.) Nasal carriage of Staph aureus is a major risk factor for surgical-site infections in orthopedic surgery: Infect Control Hosp Epidemiol. 2000 May;21(5):319-23.
4.) MRSAAssociationofMedicalMicrobiologists.(http://www.amm.co.uk/pubs/fa_mrsa.htm)
5.) Recommendations for Preventing the Spread of Vancomycin Resistance Recommendations of the Hospital Infection Control Practices Advisory Committee (HICPAC): http://aepo-xdv-www.epo.cdc.gov/wonder/prevgiud/m0039349/m0039349.asp